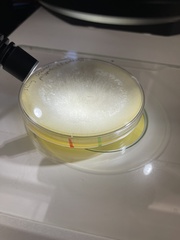
Zygomycetes

Zygomycetes: taxon details and analytics
- Domain
- Kingdom
- Fungi
- Phylum
- Zygomycota
- Class
- Zygomycetes
- Order
- Family
- Genus
- Species
- Scientific Name
- Zygomycetes
Summary description from Wikipedia:
Zygomycetes
Zygomycetes is een klasse van schimmels (Fungi) uit de stam van lagere schimmels (Zygomycota).
De soorten uit deze klasse leven op het land als saprofyt of parasiet op planten, dieren of op mensen. De ongeslachtelijke voortplanting vindt plaats via aplanosporen (niet-sterfelijke sporen) in sporangia of via conidia; de geslachtelijke voortplanting via fusie of gametangia, die resulteren in zygosporen met een dikke wand.
...Zygomycetes in languages:
- Chinese
- 接合菌綱
- Czech
- zygomycety
Images from inaturalist.org observations:
We recommend you sign up for this excellent, free service.